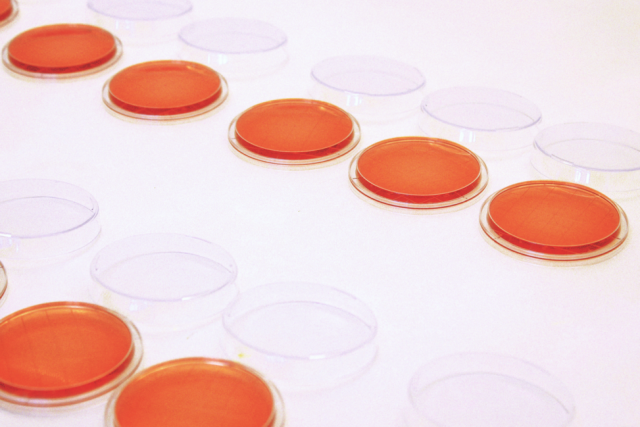

ex vivo
Ex Vivo is a film and text, resulting from a year long residency at the Luton campus of the University of Bedfordshire.
It looks at representation of science in art, and media, alongside the representation of women in both.
You can read the full text here.